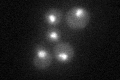
YER161C
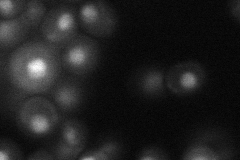
YER161C

View description
Protein involved in negative regulation of transcription; required for RNA polyadenylation; exhibits regulated interactions with both histones and SWI-SNF components, has similarity to mammalian HMG1 proteins
Localization:
Intensity:
Fold change:
Significance:
-
C’ GFP library in SD
nucleus34.86 -
N' NOP1pr-GFP in SD

nucleus53.4756 -
N' TEF2pr-mCherry in SD

nucleus54.363 -
N' NATIVEpr-GFP in SD
nucleus21.7669 -
N' TEF2pr-VC and Cyto-VN in SD

#N/A0 -
C’ GFP library in SD+DTT

nucleus33.320.95No -
C’ GFP library in SD+H2O2

nucleus32.680.93No -
C’ GFP library in Starvation Media

nucleus26.60.76No -
C’ GFP library on the background of Pup2-DaMP

nucleus -
C’ GFP library on the background of CCT mutant

nucleus37.04131.06244No
